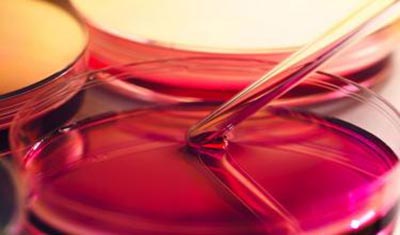

体外药效学实验-肿瘤治疗的“私人定制”
目前对于同一类型的肿瘤,临床治疗大多是基于人群数据制定的标准化方案。化疗是恶性肿瘤三大治疗方法之一,其趋势倾向于常规治疗。但各种治疗方案的个体疗效并不可预见,医生更多的是根据经验用药。而每患者的基因组成不同,肿瘤对化疗药物的敏感性存在个体差异,以及肿瘤细胞具有多重抗药性(原、继发性),导致相同药对同一类型患者的治疗效果不同,因此这种一对多的治疗方案并不能使所有患者获益。因此,如何找到更适合你的治疗方案十分重要。随着生物科技的进步,我们可以根据你的肿瘤特征谱制定个性化治疗方案。如药物敏感性实验,可以确定哪些抗癌药物对打击你的肿瘤更有效。

ATP肿瘤细胞化疗药敏检测(ATP-TCA)
该检测需要在手术中收集患者的含有恶性肿瘤细胞的组织或体液,在实验室中提取肿瘤细胞并进行体外给药培养,经ATP生物荧光法检测活细胞指标ATP,进而判断个体对抗肿瘤药物的敏感性和耐受性。具体而言,荧光素酶在有氧条件下,可与荧光素结合催化ATP转化成AMP,同时释放出生物荧光(波长为562nm),测定产生的荧光强度,可获得ATP含量。ATP含量与细胞活性状态在一定范围 内呈线性关系,通过对细胞内ATP含量(10-13~10-15mol/L)的测量可量化出药物抑制肿瘤细胞生长的效率。检测后将给药物敏感性评价报告,帮助医生做出更好的治疗决策,在治疗前筛选更敏感的药物,尽量避免毒副作用和无效治疗。